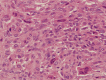

Use of denosumab in recurrent chondroblastoma of the squamous temporal bone: a case report
- PMID: 28396758
- PMCID: PMC5378851
- DOI: 10.1002/ccr3.838
Use of denosumab in recurrent chondroblastoma of the squamous temporal bone: a case report
Abstract
Chondroblastoma is a rare, benign bone tumor that represents 1-2% of all primary bone tumors. Denosumab, a monoclonal antibody, has been demonstrated to inhibit the growth of giant cell tumors. We report a case of recurrent chondroblastoma of the squamous temporal bone that is currently suppressed with denosumab.
Keywords: Bone tumor; chondroblastoma; denosumab; giant cell tumor.
Figures

References
-
- Schajowicz, F. , and Gallardo H.. 1970. Epiphysial chondroblastoma of bone: a clinicopathological study of sixty‐nine cases. J. Bone Joint Surg. Br. 52:205–226. - PubMed
-
- Dahlin, D. C. , and Ivins J. C.. 1972. Benign chondroblastoma: a study of 125 cases. Cancer 30:401–413. - PubMed
-
- Sailhan, F. , Chotel F., and Parot R.. 2009. SOFOP: chondroblastoma of bone in a pediatric population. J. Bone Joint Surg. Am. 91:2159–2168. - PubMed
-
- Ramappa, A. J. , Lee F. Y., Tang P., Carlson J. R., Gebhardt M. C., and Mankin H. J.. 2000. Chondroblastoma of bone. J. Bone Joint Surg. Am. 82:1140–1145. - PubMed
-
- Suneja, R. , Grimer R. J., Belthur M., Jeys L., Carter S. R., Tillman R. M., et al. 2005. Chondroblastoma of bone. Long‐term results and functional outcome after intralesional curettage. J. Bone Joint Surg. Br. 87:974–978. - PubMed
Publication types
LinkOut - more resources
Full Text Sources
Other Literature Sources

